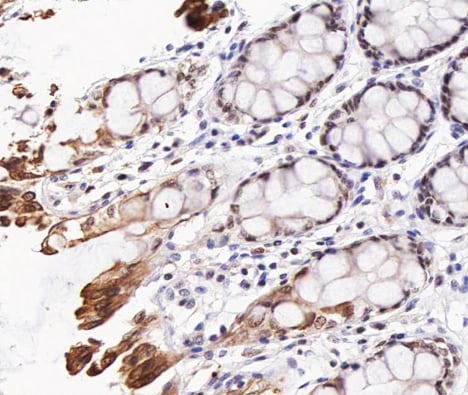
product-image-AAA321589_IHC15.jpg

Rabbit Akt Polyclonal Antibody | anti-AKT1 antibody
Phospho-Akt (Thr308) Antibody
Phosphate buffered saline, pH 7.4, 150mM NaCl, 0.02% sodium azide and 50% glycerol.
IF (Immunofluorescence)
(AAA321589 staining Hela by IF/ICC. The sample were fixed with PFA and permeabilized in 0.1% Triton X-100, then blocked in 10% serum for 45 minutes at 25 degree C. The primary antibody was diluted at 1/200 and incubated with the sample for 1 hour at 37 degree C. An Alexa Fluor 594 conjugated goat anti-rabbit IgG (H+L) Ab, diluted at 1/600, was used as the secondary antibody.)
WB (Western Blot)
(Western blot analysis of Akt phosphorylation expression in Insulin treated 293 whole cell lysates, The lane on the left is treated with the antigen-specific peptide.)
IHC (Immunohistochemistry)
(AAA321589 at 1/200 staining human colon cancer tissue sections by IHC-P. The tissue was formaldehyde fixed and a heat mediated antigen retrieval step in citrate buffer was performed. The tissue was then blocked and incubated with the antibody for 1.5 hours at 22 degree C. An HRP conjugated goat anti-rabbit antibody was used as the secondary.)
Function: AKT1 is one of 3 closely related serine/threonine-protein kinases (AKT1, AKT2 and AKT3) called the AKT kinase, and which regulate many processes including metabolism, proliferation, cell survival, growth and angiogenesis. This is mediated through serine and/or threonine phosphorylation of a range of downstream substrates. Over 100 substrate candidates have been reported so far, but for most of them, no isoform specificity has been reported. AKT is responsible of the regulation of glucose uptake by mediating insulin-induced translocation of the SLC2A4/GLUT4 glucose transporter to the cell surface. Phosphorylation of PTPN1 at 'Ser-50' negatively modulates its phosphatase activity preventing dephosphorylation of the insulin receptor and the attenuation of insulin signaling. Phosphorylation of TBC1D4 triggers the binding of this effector to inhibitory 14-3-3 proteins, which is required for insulin-stimulated glucose transport. AKT regulates also the storage of glucose in the form of glycogen by phosphorylating GSK3A at 'Ser-21' and GSK3B at 'Ser-9', resulting in inhibition of its kinase activity. Phosphorylation of GSK3 isoforms by AKT is also thought to be one mechanism by which cell proliferation is driven. AKT regulates also cell survival via the phosphorylation of MAP3K5 (apoptosis signal-related kinase). Phosphorylation of 'Ser-83' decreases MAP3K5 kinase activity stimulated by oxidative stress and thereby prevents apoptosis. AKT mediates insulin-stimulated protein synthesis by phosphorylating TSC2 at 'Ser-939' and 'Thr-1462', thereby activating mTORC1 signaling and leading to both phosphorylation of 4E-BP1 and in activation of RPS6KB1. AKT is involved in the phosphorylation of members of the FOXO factors (Forkhead family of transcription factors), leading to binding of 14-3-3 proteins and cytoplasmic localization. In particular, FOXO1 is phosphorylated at 'Thr-24', 'Ser-256' and 'Ser-319'. FOXO3 and FOXO4 are phosphorylated on equivalent sites. AKT has an important role in the regulation of NF-kappa-B-dependent gene transcription and positively regulates the activity of CREB1 (cyclic AMP (cAMP)-response element binding protein). The phosphorylation of CREB1 induces the binding of accessory proteins that are necessary for the transcription of pro-survival genes such as BCL2 and MCL1. AKT phosphorylates 'Ser-454' on ATP citrate lyase (ACLY), thereby potentially regulating ACLY activity and fatty acid synthesis. Activates the 3B isoform of cyclic nucleotide phosphodiesterase (PDE3B) via phosphorylation of 'Ser-273', resulting in reduced cyclic AMP levels and inhibition of lipolysis. Phosphorylates PIKFYVE on 'Ser-318', which results in increased PI3P-5 activity. The Rho GTPase-activating protein DLC1 is another substrate and its phosphorylation is implicated in the regulation cell proliferation and cell growth. AKT plays a role as key modulator of the AKT-mTOR signaling pathway controlling the tempo of the process of newborn neurons integration during adult neurogenesis, including correct neuron positioning, dendritic development and synapse formation. Signals downstream of phosphatidylinositol 3-kinase (PI3K) to mediate the effects of various growth factors such as platelet-derived growth factor (PDGF), epidermal growth factor (EGF), insulin and insulin-like growth factor I (IGF-I). AKT mediates the antiapoptotic effects of IGF-I. Essential for the SPATA13-mediated regulation of cell migration and adhesion assembly and disassembly. May be involved in the regulation of the placental development. Phosphorylates STK4/MST1 at 'Thr-120' and 'Thr-387' leading to inhibition of its: kinase activity, nuclear translocation, autophosphorylation and ability to phosphorylate FOXO3. Phosphorylates STK3/MST2 at 'Thr-117' and 'Thr-384' leading to inhibition of its: cleavage, kinase activity, autophosphorylation at Thr-180, binding to RASSF1 and nuclear translocation. Phosphorylates SRPK2 and enhances its kinase activity towards SRSF2 and ACIN1 and promotes its nuclear translocation. Phosphorylates RAF1 at 'Ser-259' and negatively regulates its activity. Phosphorylation of BAD stimulates its pro-apoptotic activity. Phosphorylates KAT6A at 'Thr-369' and this phosphorylation inhibits the interaction of KAT6A with PML and negatively regulates its acetylation activity towards p53/TP53.
Subunit Structure: Interacts with BTBD10 (By similarity). Interacts with KCTD20 (By similarity). Interacts (via the C-terminus) with CCDC88A (via its C-terminus). Interacts with GRB10; the interaction leads to GRB10 phosphorylation thus promoting YWHAE-binding (By similarity). Interacts with AGAP2 (isoform 2/PIKE-A); the interaction occurs in the presence of guanine nucleotides. Interacts with AKTIP. Interacts (via PH domain) with MTCP1, TCL1A AND TCL1B. Interacts with CDKN1B; the interaction phosphorylates CDKN1B promoting 14-3-3 binding and cell-cycle progression. Interacts with MAP3K5 and TRAF6. Interacts with BAD, PPP2R5B, STK3 and STK4. Interacts (via PH domain) with SIRT1. Interacts with SRPK2 in a phosphorylation-dependent manner. Interacts with RAF1. Interacts with TRIM13; the interaction ubiquitinates AKT1 leading to its proteasomal degradation. Interacts with TNK2 and CLK2. Interacts (via the C-terminus) with THEM4 (via its C-terminus). Interacts with and phosphorylated by PDPK1. Interacts with PA2G4 (By similarity). Interacts with KIF14; the interaction is detected in the plasma membrane upon INS stimulation and promotes AKT1 phosphorylation (PubMed:24784001). Interacts with FAM83B; activates the PI3K/AKT signaling cascade (PubMed:23676467). Interacts with WDFY2 (via WD repeats 1-3) (PubMed:16792529). Forms a complex with WDFY2 and FOXO1 (By similarity). Interacts with FAM168A (PubMed:23251525). Interacts with SYAP1 (via phosphorylated form and BSD domain); this interaction is enhanced in a mTORC2-mediated manner in response to epidermal growth factor (EGF) stimulation and activates AKT1 (PubMed:23300339).
Post-translational Modifications: O-GlcNAcylation at Thr-305 and Thr-312 inhibits activating phosphorylation at Thr-308 via disrupting the interaction between AKT1 and PDPK1. O-GlcNAcylation at Ser-473 also probably interferes with phosphorylation at this site. Phosphorylation on Thr-308, Ser-473 and Tyr-474 is required for full activity. Activated TNK2 phosphorylates it on Tyr-176 resulting in its binding to the anionic plasma membrane phospholipid PA. This phosphorylated form localizes to the cell membrane, where it is targeted by PDPK1 and PDPK2 for further phosphorylations on Thr-308 and Ser-473 leading to its activation. Ser-473 phosphorylation by mTORC2 favors Thr-308 phosphorylation by PDPK1. Phosphorylated at Thr-308 and Ser-473 by IKBKE and TBK1. Ser-473 phosphorylation is enhanced by interaction with AGAP2 isoform 2 (PIKE-A). Ser-473 phosphorylation is enhanced in focal cortical dysplasias with Taylor-type balloon cells. Ser-473 phosphorylation is enhanced by signaling through activated FLT3. Dephosphorylated at Thr-308 and Ser-473 by PP2A phosphatase. The phosphorylated form of PPP2R5B is required for bridging AKT1 with PP2A phosphatase. Ser-473 is dephosphorylated by CPPED1, leading to termination of signaling. Ubiquitinated via 'Lys-48'-linked polyubiquitination by ZNRF1, leading to its degradation by the proteasome (By similarity). Ubiquitinated; undergoes both 'Lys-48'-and 'Lys-63'-linked polyubiquitination. TRAF6-induced 'Lys-63'-linked AKT1 ubiquitination is critical for phosphorylation and activation. When ubiquitinated, it translocates to the plasma membrane, where it becomes phosphorylated. When fully phosphorylated and translocated into the nucleus, undergoes 'Lys-48'-polyubiquitination catalyzed by TTC3, leading to its degradation by the proteasome. Also ubiquitinated by TRIM13 leading to its proteasomal degradation. Phosphorylated, undergoes 'Lys-48'-linked polyubiquitination preferentially at Lys-284 catalyzed by MUL1, leading to its proteasomal degradation. Acetylated on Lys-14 and Lys-20 by the histone acetyltransferases EP300 and KAT2B. Acetylation results in reduced phosphorylation and inhibition of activity. Deacetylated at Lys-14 and Lys-20 by SIRT1. SIRT1-mediated deacetylation relieves the inhibition.
Similarity: Binding of the PH domain to phosphatidylinositol 3, 4, 5-trisphosphate (PI(3, 4, 5)P3) following phosphatidylinositol 3-kinase alpha (PIK3CA) activity results in its targeting to the plasma membrane. The PH domain mediates interaction with TNK2 and Tyr-176 is also essential for this interaction.The AGC-kinase C-terminal mediates interaction with THEM4. Belongs to the protein kinase superfamily. AGC Ser/Thr protein kinase family. RAC subfamily.
NCBI and Uniprot Product Information
Predicted: 56 kDa
Customer Reviews
Loading reviews...
Share Your Experience
Similar Products
Product Notes
The AKT1 akt1 (Catalog #AAA321589) is an Antibody produced from Rabbit and is intended for research purposes only. The product is available for immediate purchase. The Phospho-Akt (Thr308) Antibody reacts with Human, Mouse, Rat and may cross-react with other species as described in the data sheet. AAA Biotech's Akt can be used in a range of immunoassay formats including, but not limited to, ELISA, ICC (Immunocytochemistry), IF (Immunofluorescence), IHC (Immunohistochemistry), WB (Western Blot). Researchers should empirically determine the suitability of the AKT1 akt1 for an application not listed in the data sheet. Researchers commonly develop new applications and it is an integral, important part of the investigative research process. It is sometimes possible for the material contained within the vial of "Akt, Polyclonal Antibody" to become dispersed throughout the inside of the vial, particularly around the seal of said vial, during shipment and storage. We always suggest centrifuging these vials to consolidate all of the liquid away from the lid and to the bottom of the vial prior to opening. Please be advised that certain products may require dry ice for shipping and that, if this is the case, an additional dry ice fee may also be required.Precautions
All products in the AAA Biotech catalog are strictly for research-use only, and are absolutely not suitable for use in any sort of medical, therapeutic, prophylactic, in-vivo, or diagnostic capacity. By purchasing a product from AAA Biotech, you are explicitly certifying that said products will be properly tested and used in line with industry standard. AAA Biotech and its authorized distribution partners reserve the right to refuse to fulfill any order if we have any indication that a purchaser may be intending to use a product outside of our accepted criteria.Disclaimer
Though we do strive to guarantee the information represented in this datasheet, AAA Biotech cannot be held responsible for any oversights or imprecisions. AAA Biotech reserves the right to adjust any aspect of this datasheet at any time and without notice. It is the responsibility of the customer to inform AAA Biotech of any product performance issues observed or experienced within 30 days of receipt of said product. To see additional details on this or any of our other policies, please see our Terms & Conditions page.Item has been added to Shopping Cart
If you are ready to order, navigate to Shopping Cart and get ready to checkout.